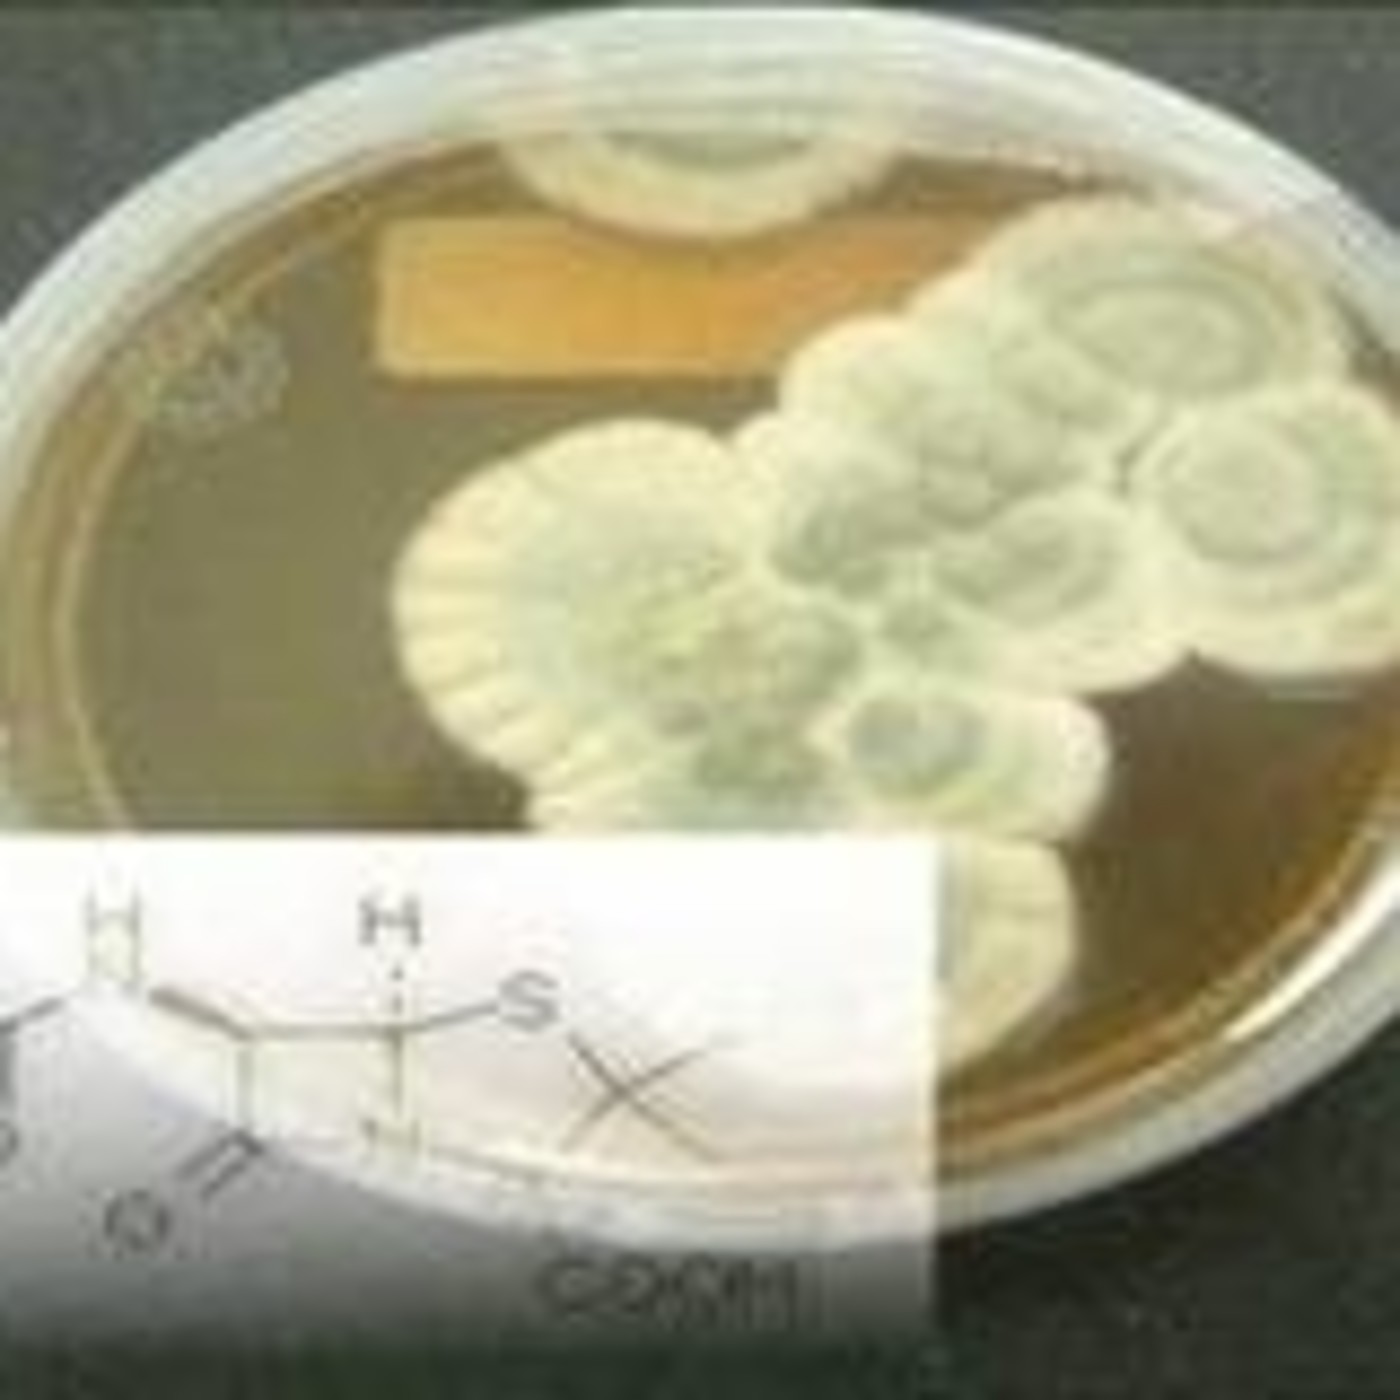
RCENI

Shows

RCENIEl negocio de las patentes y vacunasEl negocio de las patentes y las vacunas con los siglos se ha consolidado el reciente escando la farmacéutica Pfizer lo deja en perfecta evidencia el lucro y ganar dinero es lo que realmente importa a sus dueños sin importar para nada la vida humana
2019-06-1611 min
RCENILA FONOTECA De Fakear a Petit Biscuit: los jóvenes talentos de la electrónica francesa.En esta edición de la Fonoteca presentaremos a algunos de los más jóvenes beatmakers franceses, un término designaba a los músicos que un principio componían la base, el ritmo, por así decirlo, del hip hop y del rap. Pero poco a poco este término empezó a aplicarse a muchos músicos que crean lo que el gran público conoce como música electrónica, y que al mismo tiempo huyen del famoso calificativo DJ.
2018-01-0827 min
RCENIPaíses en conflicto - Violación de los derechos fundamentales.69 años después de la proclamación de la Declaración Universal de los Derechos Humanos, sus 30 artículos siguen siendo violados a lo largo y ancho del planeta. En Países en conflicto escuchamos los testimonios de quienes no ven respetados sus derechos fundamentales.
2018-01-0711 min
RCENIPlaneta Vivo. Restricciones a los más contaminantes.Barcelona es la primera ciudad del Estado en utilizar las etiquetas ambientales de la DGT para reducir la contaminación. El 1 de diciembre se empezó a aplicar el protocolo para restringir el tráfico a los vehículos más contaminantes en caso de episodio de contaminación por dióxido de nitrógeno. En estos episodios de contaminación se prohíbe la circulación a los turismos de gasolina anteriores al año 2.000 y los diésel previos a 2006 además de las furgonetas anteriores a octubre de 1994. Una prohibición que será permanente a partir de 2020. Las infracciones se...
2018-01-0702 min
RCENI5 minutos para la cooperación. Ayuda a los niños Sirios.Cinco millones setecientos mil niños sirios se han visto afectados por la guerra y necesita ayuda según Unicef. La agencia de la ONU para la infancia, trata de proporcionarles alimentos, agua, ropa de abrigo y educación. Hay zonas del país que se encuentra en conflicto, adonde no se puede acceder de forma regular.
2018-01-0706 min
RCENIPaíses en conflicto - Mujeres al volante en Arabia Saudí.Arabia Saudí permitirá conducir a sus mujeres gracias a un decreto real, el único país del mundo que aún lo prohibía. Pero el sistema de tutelaje sigue vigente en la monarquía del Golfo y para sus activistas la lucha continúa.
2017-11-1212 min
RCENI5 minutos para la Cooperación - Al lado de las víctimas en Colombia.Viajamos a Colombia y conocemos, junto a Cáritas Española, la realidad de la población del departamento del Chocó por culpa del conflicto armado. Décadas de enfrentamientos entre guerrillas, paramilitares y fuerza pública que han afectado la vida de miles de personas y que hoy, a pesar de los acuerdos con las FARC, todavía se ven sometidos a la violencia. Visitamos Istmina y Bojayá, donde la organización humanitaria de la Iglesia acompaña a las comunidades que vivien lugares donde ayer y hoy, todavía las víctimas esperan pasar página. Uno de los que vivie...
2017-11-0808 min
RCENIPlaneta vivo - ¿Qué está pasando con los insectos?¿Dónde han volado los insectos? Hace décadas que los científicos se hacen esta pregunta. La novedad es que si la revista Science se cuestionaba hace poco dónde habían ido a parar los insectos de nuestra infancia, sí esos que protagonizan lo que los expertos llaman el fenómeno del parabrisas. Recordáis aquellos trayectos en coche cuando éramos pequeños? en los que llegábamos al destino con la luna del coche llena de bichos aplastados contra el cristal? Pues ahora ni con Land Rover, que tiene la luna casi vertical, llegas a destino con bichos aplas...
2017-11-0703 min
RCENIPlaneta vivo - La economía del aguaLa crisis hídrica que amenaza las cuencas mediterráneas donde hay que gestionar sequías e inundaciones o el quinto año consecutivo de sequía que azota gran parte de la península, una de las peores de los últimos 20 años con acuíferos secos, son algunos de los temas debatidos en el Sexto Foro de la Economía del Agua, que ha reunido a 18 expertos internacionales en Barcelona.
2017-10-1703 min
RCENIEl pop ibérico cantado en francésMuchos grupos intentan traspasar fronteras para buscar reconocimiento fuera de su país y algunos pocos, con empeño y bastante sacrificio, han sabido encontrar la fórmula del éxito que les permite perpetuar su sello fuera de casa. En la emisión de hoy, abrimos la frontera sureña de Francia para escuchar los cantantes o grupos españoles que se han hecho conocer en el Hexágono durante las últimas décadas. Hoy en la Fonoteca, ¡paso a la generación pop ibérica que se atrevió a cantar en francés!
2017-09-0628 min
RCENIPlaneta vivo - Disfruta un verano sostenible -Para que todos podamos disfrutar de un verano sostenible hoy nos hacemos eco de las recomendaciones de la organización medioambiental Ecoembes que nos recuerda que si visitamos parques nacionales y naturales procuremos que la única huella que dejemos sea la de nuestros zapatos. Especies autóctonas y endémicas podrían estar en peligro sin la protección adecuada. También que no arrojemos basura en sitios inapropiados. Una simple botella de plástico tarda cientos de años en degradarse, y además depositarla en el contenedor amarillo le dará una segunda vida.
2017-08-2102 min
RCENIPaíses en conflicto - Cambiando sus mundos.Sheda nació en un campo de refugiados palestinos en el que imparte formación medioambiental. Rachana nació en Nepal y dirige un centro comunitario para el empoderamiento de las mujeres. Ambas decidieron actuar para cambiar sus realidades.
2017-08-2111 min
RCENIPlaneta vivo - Plásticos de vacacionesEstos días en los que la mayoría estaréis disfrutando de unas merecidísimas vacaciones, muchos en la playa o en la montaña, son una buena oportunidad para comprobar la cantidad de plástico que acaba en la naturaleza.
La mayoría del plástico que contamina las costas se oculta en la arena en trozos muy pequeños resultado de su degradación. El origen de estos plásticos es nuestros residuos terrestres que por mala gestión, acaban en nuestros mares y los que se arrojan desde los barcos tanto pesqueros como de transporte marítimo o de tur...
2017-08-1002 min
RCENILA FONOTECA.- Serendipia, el azar al servicio de la música.La serendipia es un hallazgo afortunado inesperado que se aplica a las ciencias pero también al arte y a la música. En este programa les hablamos de algunos de esos errores, accidentes, olvidos o circunstancias que marcaron la historia de algunos artistas o incluso que supusieron un antes y un después para la evolución de la música. Serendipias como una linea de bajo reproducida al revés, un amplificador en mal estado que provoca la distorsión de una guitarra o una resaca monumental de una banda que inventará sin saberlo el Garage Rock
2017-08-1027 min
RCENI5 Minutos para la Cooperación. Indígenas con derecho ColombiaEl proceso de paz en Colombia abre la puerta a que colectivos que han estado históricamente en medio de los bandos en combate, tengan nuevas oportunidades. La Fundación Caminos de Identidad, con el apoyo de Manos Unidas, intentan pelear por los derechos de los colectivos indígenas como los wayuu, un grupo brutalmente olvidado y que exige su derecho a una vida digna en su tierra. Hablamos con su fundadora, Ruth Chaparro que ha recogido el premio Bartolomé de las Casas.
2017-07-3105 min
RCENIPaíses en conflicto. Yemen, guerra y cólera.Dos años y medio de guerra en Yemen y la peor crisis humanitaria de la actualidad sigue agravándose. A los combates y bombardeos, al hambre y al desplazamiento se suma ahora el peor brote de cólera de los últimos tiempos.
2017-07-3112 min
RCENI5 minutos para la Cooperación - Teatro en MadagascarUn profesor de teatro de la Escuela de Alcorcón, Francisco Portillo, prepara y representa obras teatrales por poblados de Madagascar. Es un proyecto cultural solidario dirigido a personas que nunca antes han tenido contacto con el mundo de la interpretación.
2017-07-2405 min
RCENILA FONOTECA El flechazo de -M- por la música malienseEsta es la historia de un encuentro con un país, su música, su gente. En esta edición de la Fonoteca, les proponemos descubrir el sexto álbum del prolífico cantante y compositor francés Matthieu Chedid alias -M-. En este disco afro pop, homenaje a Mali, el sonido cristalino y delicado de la kora, un instrumento africano entre el arpa y el laúd, juega con la guitarra eléctrica.
De raices egipcias y libanesas, el francés Matthieu Chedid descubrió Mali gracias a su amistad con la pareja de cantantes malienses Amadou y Mariam y con los años e...
2017-07-1928 min
RCENIPaíses en conflicto - La ruta de la torturaEl 30% de las personas rescatadas por Médicos Sin Fronteras en el Mediterráneo han sido víctimas de tortura. Una práctica que sigue siendo habitual en países de todo el mundo. También en las principales rutas migratorias.
El espacio Países en conflicto, un programa de Radio 5 cuyo objetivo es analizar en profundidad y con conciencia conflictos y crisis humanitarias, con la intención de denunciar injusticias y contribuir al cumplimiento de los derechos humanos, nos habla en esta ocasión de migrantes y refugiados víctimas de tortura.
2017-07-1910 min
RCENIPaíses en conflicto - Rompiendo las reglasMaria Toorpakai nació en la región tribal de Pakistán y luchó desde muy pequeña hasta convertirse en deportista. Roya Mahboob nació en Afganistán y fue la primera Directora Ejecutiva de su país. Ambas, amenazadas. Ambas, mujeres rompiendo las reglas
2017-07-1212 min
RCENIPlaneta vivo - Abejas y neonicotinoidesDos nuevos estudios científicos, publicados en la revista Science, advierten que el uso de unos insecticidas derivados de la nicotina, los llamados insecticidas neonicotinoides, perjudica a las abejas silvestres y a las que producen miel.
La primera investigación, realizada por el Centro de Ecología e Hidrología de Oxfordshire, se llevó a cabo en campos del Reino Unido, Alemania y Hungría, cuyos cultivos fueron tratados con este tipo de pesticidas y en los que los científicos comprobaron la muerte de más del 20 por ciento de las abejas.
En marzo de 2017, la Comisión Europea propuso u...
2017-07-1202 min
RCENI5 minutos para la Cooperación - La escuela como refugio en Chad.Viajamos junto a UNICEF hasta el lago Chad, en el corazón de África. No se habla mucho de la gigantesca emergencia humana que vive este lugar por la pobreza eterna empeorada en los últimos años por la brutalidad de Boko Haram. Sobre el terreno conocemos el trabajo que se hace en las escuelas que se han convertido en el lugar clave para garantizar la seguridad y el futuro de los más pequeños.
2017-07-0905 min
RCENILA FONOTECA El regreso de la pop refrescante de PhoenixSe inspiran de los Jackson, de Prince, los Beatles, los Velvet Underground o de Gainsbourg, y ahora vuelven con un nuevo álbum que nos lleva a Italia... Hablamos de uno de los grupos franceses de pop indie que mejor se ha exportado, en particular a Estados Unidos: Phoenix. En este 2017, el cuarteto que viene de Versalles vuelve con un sexto álbum, Ti Amo, un paréntesis veraniego, un manifiesto hedonista, una declaración de amor a Italia…
Lista de temas en la Fonoteca de hoy:
"J-Boy"
"If I Ever Feel Better"
"Too Young"
"1901"
"Entertainment"
"Ti Amo"
"Telefono"
"Goodbye Soleil"
2017-07-0327 min
RCENIPlaneta vivo.- La sed de DoñanaYa antes de que estos días empezara a arder parte del Parque Natural de Doñana, con un incendio que nunca debiera haber ocurrido, el coto ya precisaba de muchísima agua. Días antes del inicio del fuego, el 25 de junio, la Junta de Andalucía y Heineken España finalizaron los trabajos para recuperar tres humedales que retornan al parque casi medio millón de litros de agua al año para saciar la sed de la marisma, 420 millones de litros para retornar hasta la última gota que utiliza en la fabricación de sus cervezas en la planta...
2017-07-0302 min
RCENI5 minutos para la Cooperación- Emergencia en República CentroafricanaEn República Centroafricana se ha reavivado el conflicto armado y la población civil se encuentra en una situación muy vulnerable. La violencia va en aumento y hay miles de desplazados. Médicos Sin Fronteras España gestiona cuatro proyectos en el país con los que presta apoyo sanitario de emergencia.
2017-07-0305 min
RCENIPaíses en conflicto.- Activistas trans.Personas transexuales siguen sufriendo el estigma y la discriminación. Y en algunos países, criminalización. Así crecieron Erika en Belice y Alessandra en Honduras, hasta que decidieron alzar la voz y convertirse en activistas. Estas son sus historias.
2017-07-0312 min
RCENI180 grados - Arcade Fire, Yonaka, Twin Peaks y Las Eléctricas.Empezamos con la nueva obra de arte de Arcade Fire, 'Creature Comfort', seguimos con un cuarteto de Brighton llamado Yonaka, escuchamos, desde Australia, a Jen Cloher, una canción nueva de Twin Peaks para un recopilatorio de verano y a una banda formada por seis niñas y un niño, de entre 10 y 13 años, que se llaman Las Eléctricas y que hoy cierran el primer festival de música celebrado en 'Sonidópolis', en Gijón, una cita dirigida por Petit Pop.
ARCADE FIRE - Creature Comfor, YONAKA - Wouldn’t Wanna Be Ya, JEN CLOHER feat COURTNEY B...
2017-06-2559 min
RCENIJesucristo es de origen extraterrestre y el Vaticano lo sabe.JESUCRISTO ERA UN HIBRIDO EXTRATERRESTRE Y EL VATICANO LO SABE
Dios es creador de todo incluido el mundo (la Tierra) entonces lógicamente Dios es extraterrestre pues no es de origen terrestre, y según la creencia cristiana Jesús es hijo de Dios y de la virgen María entonces lógicamente es hibrido y de origen extraterrestre.
Y además Jesús mismo decía mi reino NO ES DE ESTE MUNDO
2017-06-2508 min
RCENILas 10 Mejores curiosidades del universo.El universo es la totalidad del espacio y del tiempo, de todas las formas de la materia, la energía y el impulso, las leyes y constantes físicas que las gobiernan. Sin embargo, el término también se utiliza en sentidos contextuales ligeramente diferentes y alude a conceptos como cosmos, mundo o naturaleza
2017-06-2405 min
RCENIPaíses en conflicto - Dos historias de refugiadosEn 2016 el número de personas refugiadas y desplazadas en el mundo superó los 65 millones, un incremento de un 55% en cuatro años. En Países en conflicto, las historias de dos de ellas.
2017-06-2410 min
RCENILa Fonoteca del cosmos.Como si fuese un inagotable recurso a la hora de componer melodías, hoy indagaremos en el mundo del cosmos y su universo. Una gran fuente de inspiración para muchos compositores que se inspiran en las leyes naturales y en los objetos que pueden ser vistos en el cielo. Hoy en la Fonoteca de RFI exploramos la música francesa a través de planetas, galaxias y todo lo que tenga que ver con el universo. Bienvenidos al cosmos de la canción francófona…
Lista de temas en la Fonoteca de hoy:
“J'ai demandé à la Lune” – Indochine
“La femme étoile” – Ar...
2017-06-1828 min
RCENI180 Grados - Electric Nana, The Killers, Everything Everything y LIVNos hace especial ilusión la sesión de hoy porque compartimos contigo el estreno de las dos nuevas canciones de Electric Nana con las que ella se toma un respiro musical: 'High' y 'Hold Tight'. La madrileña encabeza esta hora en la que también aparece lo nuevo de los ingleses Everything Everyhting, de The Fresh & Onlys, de esa superbanda que cuenta con la presencia de Lykke Li junto a componentes de Miike Snow y de Peter, Björn & John (nos lo cuenta Leyre Guerrero) y, por supuesto, el avance del próximo disco de The Killers. Se llama...
2017-06-1758 min
RCENI5 minutos para la Cooperación - Reconstrucción tras el ciclón.Arquitectos Sin Fronteras ha colaborado en la reconstrucción de los centros de salud dañados tras el paso del ciclón Dineo, en la costa sur de Mozambique. Meses después quedan decenas de edificios de la administración afectados por las fuertes rachas de viento y la lluvia torrencial que cayó en febrero.
2017-06-1505 min
RCENI7 Descubrimientos Accidentales Que Cambiaron El MundoHOLA HOLA HOY TE MOSTRARE 7 DESCUBRIMIENTOS ACCIDENTALES QUE CAMBIARON EL MUNDO
Una casualidad o un accidente. Puede sorprenderte saber que algunos de los inventos más útiles del mundo no fueron planeados y probados en absoluto, sino que fueron accidentes, así que aquí te mostrare algunos
7 Descubrimientos Accidentales Que Cambiaron El Mundo
NUMERO 1. Penicilina
NUMERO 2 CELOFAN
NUMERO 3 Rayos X
NUMERO 4 Teflón
NUMERO 5 Sildenafil
NUMERO 6 Vidrio De Seguridad
NUMERO 7 cerillos
2017-06-1104 min
RCENI5 Razas de alienígenas que caminan entre nosotros (Extraterrestre en la tierra)Increíbles relatos de 5 razas extraterrestres que han compartido con los humanos y su desarrollo, como nos han acompañado y tutelado a través de miles de años, quizás sea algo difícil de entender para quienes no están en sintonía en este tema sin embargo para otros radio escuchas esto simplemente confirma la sospecha que tienen sobre las diferentes teorías de los extraterrestres. El documental está muy bien hecho y el relato está cargado de información.
Todo lo que decimos en este canal no es creación nuestra solo damos una noticia que se cuenta...
2017-06-1110 min
RCENIPlaneta vivo - Innovate4ClimatePasar de una economía basada en los combustibles fósiles a otra sostenible de energías renovables precisa más de 20 billones, con b, de dólares en potenciales inversiones hasta 2030. Son estimaciones del Banco Mundial que también prevé que en los próximos 15 años, el gasto mundial en infraestructuras sobrepasará los 90 billones de dólares. Es la mayor inversión hasta la fecha y la mayor parte se tendría que hacer en los países en desarrollo.
Activar a corto plazo estas billonarias inversiones previstas en los Acuerdos de París de 2015 ha sido el principal objet...
2017-06-1102 min
RCENIPaíses en conflicto - Violencia en AfganistánEn tan solo tres días, más de un centenar de personas han muerto en Kabul en atentados y ataques. Afganistán registra niveles récord de violencia casi 16 años después de la invasión de Estados Unidos.
2017-06-1110 min
RCENI180 grados - Phoenix, Waxahatchee y Matt MaltesePhoenix siguen compartiendo las canciones del disco que publican este viernes y hoy lo hacen con 'Goodbye Soleil', la portada de esta mañana. Seguimos con sonidos veraniegos a cargo del cuarteto británico Pelicandy, escuchamos a un tipo, de apenas 20 años, ubicado en Londres y llamado Matt Maltese, entre Father John Misty y Rufus Wainwright y conocemos una nueva canción de Waxahatchee, 'Never Been Wrong'.
PHOENIX - Goodbye Soleil, PELICANDY - Animals, LUIS BREA y EL MIEDO - Nueva Generación, NINE INCH NAILS - Everything, MATT MALTESE - No One Won The War, ARCADE FIRE - Every...
2017-06-0958 min
RCENILA FONOTECA. Música para los cinco sentidos.Fue el creador de la lógica, Aristóteles, uno de los más grandes filósofos de la Antigüedad, quien trató por primera vez en la historia la existencia de cinco sentidos básicos en el ser humano. Sin querer entrar en el mundo de la filosofía hoy utilizaremos la música como vía principal para despertar todos nuestros sentidos. Nos dejaremos tocar por sensaciones rítmicas, escucharemos diferentes estilos musicales, pondremos visión a melodías, degustaremos alguna que otra composición y descubriremos a qué huelen las canciones. En definitiva, intentaremos que la música pueda ser r...
2017-06-0528 min
RCENI10 Señales De Vida Extraterrestre En La Tierra.Bienvenido a Doc Tops. Desde gobernantes reptilianos hasta los verdaderos hombres de negro, estos son 10 señales o posibles evidencias de vida extraterrestre y de ovnis en la tierra.
Los Ovnis u objetos voladores no identificados han sido por décadas un tema que muchas personas han intentado descifrar. Las evidencias presentadas, en la mayoría de los casos o mejor dicho en todos, ha sido demostrada ser falsa pero aun así existe la posibilidad de que no estemos solos o que el gobierno nos este ocultando algo. Los alienígenas o extraterrestres podrían estar más cerca de lo que
2017-06-0409 min
RCENIPlaneta vivo - Bosques verticales en ChinaLos bosques verticales se plantan en Asia, concretamente en China, uno de los países más contaminados y contaminantes del planeta. El continente asiático tendrá en 2018 su primer bosque vertical con las Torres Nanjing Green, del arquitecto italiano Stefano Boeri, creador del exitoso Bosque Vertical de Milán, en 2014, que posteriormente emuló Suiza. China es ahora, pues, el tercer país del mundo en implementar este diseño
2017-06-0402 min
RCENIMundo desconocido.- Señales de Otros MundosRecientemente, se han detectado múltiples señales de diversas partes del universo, estas señales han sido descubiertas por un nutrido grupo de astrónomos en dos radiotelescopios australianos, uno de esos astrónomos, comenta que pueden pertenecer a una civilización extraterrestre que hasta ahora desconocíamos.
En el siguiente audio,hablamos de estas señales y su extraño comportamiento.
2017-05-3006 min
RCENIPaíses en conflicto - LGTfobia76 países en el mundo cuentan aún con leyes que penalizan o discriminan a personas por su orientación sexual o identidad de género. En Países en conflicto, los testimonios de cuatro de ellas.
2017-05-2712 min
RCENIPlaneta vivo - Contaminación de ecosistemas marinosEntre las amenazas de contaminación que acechan la sostenibilidad de los ecosistemas costeros hay un nuevo grupo denominado contaminantes emergentes, que incluyen compuestos de distinta naturaleza química procedentes de fármacos o productos de higiene personal, y cuyos efectos apenas se conocen.
2017-05-2702 min
RCENILA FONOTECA. El reggae francésNacido como expresión cultural a finales de los años 60 en Jamaica, el reggae ha sido uno de los géneros musicales que mejor se han expandido hasta nuestros días por todos los continentes del mundo. En Francia, este estilo musical desembarcaba en los 70 y a pesar de ser en un principio un producto que se gestionaba en circuitos cerrados, se expandió rápidamente al público de masas gracias a una conocida versión de la Marsellesa creada por el genio Gainsbourg. Tal ha sido su recorrido en Francia que actualmente representa uno de los mercados más importa...
2017-05-2627 min
RCENI5 Minutos para la Colaboración.- Meningitis en Nigeria.Un brote de Meningitis C detectado en el norte de Nigeria ha dejado más de un millar de muertos y miles de afectados. La responsable médica de Médicos Sin Fronteras para este país africano nos habla de la incidencia y los riesgos de la enfermedad.
2017-05-2205 min
RCENIPlaneta vivo.- China y la Contaminación.En numerosos puntos del país, como la ciudad industrial Tangshan, la sexta ciudad más contaminada del país, se cierne una espesa niebla gris. Es en la provincia de Hebei, donde también están las cinco primeras ciudades más contaminadas de China. El humo del carbón procedente de las fábricas y centrales eléctricas de la región se desplaza hacia Pekín y contribuye a los conocidos y temidos «airepocalipsis» en la capital.
2017-05-2102 min
RCENI5 Lugares Más Misteriosos Del MundoHay sitios que ni los más valientes se atreven a ir. En este programa podrás conocer los 5 Lugares Más Misteriosos Del Mundo (Bosque Aokigahara, Mansión Guirola Y Lugares de cual te explicaremos)
2017-05-2110 min
RCENIEl HACKER QUE VIO TODOS LOS SECRETOS OVNI DE LA NASA Y LA ÉLITE: Impactantes Revelaciones.El Británico Gary McKinnon pagó muy cara su osadía de infiltrarse dentro de las redes secretas de la NASA y otros organismos elitistas. Condenado a 70 años de cárcel, McKinnon estuvo durante un año, recopilando fotografías e informes secretos sobre OVNIS y extraterrestres, naves estrelladas, tecnología inversa y otros impactantes descubrimientos
2017-05-2110 min
RCENIPaíses en Conflicto.- Ruta Centroamericana.9 de cada 10 migrantes y refugiados atendidos por Médicos Sin Fronteras han sufrido un episodio de violencia en sus países de origen, la mayoría en Centroamérica, o a lo largo de la ruta migratoria hacia México y EEUU. Doblemente víctimas en una crisis humanitaria olvidada.
2017-05-2111 min
RCENIPlaneta vivo - PAGES 2017Hay cambios con los que vamos a tener que aprender a convivir, pero todavía estamos a tiempo de parar los peores efectos del cambio climático". Son palabras de la investigadora australiana Nerilie Abram, pronunciadas en la inauguración del Congreso Internacional Sobre Cambios Climáticos y Ambientales PAGES 2017, que reúne en Zaragoza a casi un millar de científicos de 51 países para abordar los retos climáticos a los que nos enfrentamos. Un mensaje de esperanza lanzado en el principal foro mundial sobre paleoclima, que se celebra hasta este sábado 13 de mayo en la capital aragonesa...
2017-05-1502 min
RCENILa Impactante Historia Oculta en Interstellar.Hoy vamos hablar de La Impactante Historia Oculta en la película Interstellar muchos mensajes se encuentran para descubrirlos te invitamos a que nos acompañes. la humanidad alcanzada por su destino en un futuro muy cercano,busca refugiarse, en otros mundos que hay detrás de todo esto.
2017-05-1409 min
RCENIPaíses en Conflicto.- El periodismo sigue vivoReporteros Sin Fronteras afirma que el mapa de la libertad de prensa en el mundo es cada vez más sombrío y que ésta se encuentra cada vez más amenazada. Pero profesionales a lo largo y ancho del planeta luchan por arrojar luz en una época tan oscura.
2017-05-1411 min
RCENIMundo Desconocido.-No es el año 2017, estamos en 1720Hacer esta afirmación resulta audaz, pero cuando usted escuche las explicaciones que entregan varios historiadores alemanes sobre cómo adelantaron 300 años de golpe el calendario en el medievo, verá que tal idea, no solo es posible, si no que muy probable, No estamos en 2017… estamos en 1720.
2017-05-0815 min
RCENICuriosidades y datos interesantes del mundoDatos curiosos que quizás algunos sean conocidos y otros, narrados de forma amena.
2017-05-0711 min
RCENIPaíses en Conflicto.- crisis 2017Naciones Unidas ha realizado un llamamiento humanitario récord para 2017. Más de 20.000 millones de euros para cubrir las necesidades básicas de 93 millones de personas en 33 países afectados por diversas crisis. Siria, Irak, Sudán del Sur, Nigeria o Afganistán son algunas de las catástrofes a las que seguir prestando atención a lo largo de este año.
2017-05-0711 min
RCENILa Impactante Historia Oculta en The MatrixHoy vamos hablar sobre la película Matrix, los paralelismos de Neo con Jesucristo y el mito de la caverna de platón.
2017-05-0209 min
RCENILa Fonoteca.-El nuevo jazz con sabor francés.El jazz, género musical nacido a finales del siglo XIX en Estados Unidos, tomó raíces en la cultura francesa que lo sigue celebrando. Cada año aparecen nuevas figuras de la escena del jazz nacional reconocido en todo el mundo. Con el inicio del año nuevos discos fueron lanzados por los músicos y en pocos días comenzará el festival de blues y jazz de los suburbios de París, Banlieues Bleues. Durante casi dos semanas decenas de artistas locales y algunos internacionales darán a conocer sus recientes composiciones o volverán a visitar los clásicos qu...
2017-04-3027 min
RCENIPlaneta vivo - Natura 2000 cumple 25 añosNatura 2000 cumple su primer cuarto de siglo y para celebrarlo Europa está ultimando un plan para mejorar la red que en su 25 aniversario se ha consolidado como la red de espacios protegidos más extensa del mundo y como el principal instrumento para la conservación de la biodiversidad de Europa.
Y es que Natura 2000 es vital para Europa. Su papel es determinante para la conservación de los espacios y de las especies más valiosos. En total, Europa tiene 27.300 espacios incluidos en la red que suman 1,15 millones de kilómetros cuadrados, el 18 por ciento de la superficie terrestre de la...
2017-04-3003 min
RCENIPaíses en conflicto - Violencia en MéxicoMéxico es uno de los países más peligrosos del mundo para ejercer el periodismo. 2016 cerró como el año más letal con 11 profesionales asesinados y 426 agresiones.
2017-04-3011 min
RCENI180 Grados - Ratboy, Soulwax y Kendrick LamarMúsica de un joven en un Reino Unido post Brexit. Así se define el último trallazo que ha lanzado Rat Boy. También el nuevo disco de Soulwax y 'Humble', todo lo que conocemos por ahora del nuevo disco de Kendrick Lamar que sale mañana con colaboración de U2 incluida.
PLAYLIST: NIÑOS MUTANTES - 'Menú del día'; LUIS BREA & EL MIEDO - 'Nueva Generación'; COSMEN ADELAIDA - 'Contra la pared'; CALA VENTO - 'El mejor momento de mi vida'; RAT BOY - 'Revolution'; GORILLAZ - 'Let me out'; KENDRICK LAMAR - 'Humble'; BEYONCÉ FT. KENDRICK LA...
2017-04-2758 min
RCENINikola Tesla ¿Qué es lo que REALMENTE descubrió?El doctor Nikola Tesla era considerado como una de las personas más conocidas de la Tierra. Hoy en día ha desaparecido de nuestros libros científicos y de los libros de texto.
¿Qué es lo que descubrió, por lo que cayó en olvido?
Bienvenidos a Libre Pensar, hoy presentamos la Historia de Nikola Tesla. ¿Qué es lo que realmente descubrió?
2017-04-2610 min
RCENILa Fonoteca.-Los nuevos artistas de la escena francesa.En esta Fonoteca vamos a descubrir nuevos artistas franceses. Algunos nos llegan desde el underground local mientras que otros ofrecen nuevas perspectivas de estilos tradicionales de la canción francesa. Laura Cahen, Nirman, Paul d’Amour, Bertrand Burgalat, Rach Three… ¡Para su deleite!
Lista de temas en la Fonoteca de hoy:
“Froid”, Laura Cahen
“Azzam David”, Nirman
“Je l'adore”, Paul d'Amour
“Dubai My Love”, Bertrand Burgalat
“Further North”, Rach Three
“The Stars”, Rach Three
2017-04-2327 min
RCENIPlaneta Vivo.- Lo que oleaje se llevoSe acerca el buen tiempo y volvemos a invertir ingentes recursos económicos, materiales y humanos en poner las playas a punto para el la nueva temporada turística. Como cada año, la erosión se ha llevado la arena. Muchísimas infraestructuras turísticas colocan defensas para protegerse de las olas. Algo que se repite a lo largo de la costa española, erosionada por, entre otros motivos, la construcción de demasiadas barreras.
Para frenar la erosión del litoral, un estudio de la Universidad Politécnica de Cataluña, la UPC, propone, por primera vez en España, rep...
2017-04-2203 min
RCENI5 Minutos para la cooperación.- Educación para la PazLa Asociación Mundial de Educadores Infantiles, AMEI, divulga su programa de Educación para la Paz para promover la convivencia en armonía entre los más pequeños. Su última intervención en terreno ha sido en Palestina, donde la ONG española ha sido invitada por la oficina de UNICEF.
2017-04-2205 min
RCENICurioso Mundo.-10 Datos curiosos del océanosPara empezar sabias que el 93% de toda la vida en la tierra, vive en el océano, esto quiero decir que todos los animales terrestres, ya sean mamíferos, plantas o insectos solo conformamos un pequeño 7% de todos los seres vivientes del planeta? Mientras que el restante 93% es conformado por peces, corales, plankton y millones de distintas especies más.
2017-04-2007 min
RCENI5 Minutos para la Cooperación - Emergencia total en el Lago ChadAunque no se hable mucho, en el entorno del Lago Chad hay más de ocho millones de personas que necesitan ayuda de manera urgente. Los ataques de Boko Haram y la respuesta militar de los ejércitos de Nigeria, Níger, Chad y Camerún sitúan en medio a una población que ha huído de sus casas pero que ni siquiera encuentra tranquila fuera de sus países. Hablamos con Lilian Kastner, responsable de Emergencias de UNICEF en Chad que nos explica de primera mano por lo que está pasando la población.
2017-04-1405 min
RCENIPlaneta Vivo.- Reciclamos mas.En los últimos años, nuestra conciencia ecológica se ha disparado y ya reciclamos un 75 % frente al 5 % de 1998.
Los que más residuos generan son los andaluces, con más de 4.500 toneladas al año, y los que menos los riojanos, con 81 toneladas. Las actividades que más residuos generan son el comercio al por menor, con casi un 24 %, y al por mayor e intermediarios, con cerca del 23 %.
2017-04-1402 min
RCENIPaíses en Conflicto.- Yemen al borde de la HambrunaYemen es una de las cuatro regiones del planeta que Naciones Unidas considera al borde de la hambruna. Más de 14 millones de sus habitantes tienen dificultades para acceder a los alimentos que necesitan tras casi dos años de cruenta guerra en el país más empobrecido del mundo árabe.
2017-04-1411 min
RCENILas 5 personas más misteriosas de la historia.A lo largo de la historia, se han conocido personas extraordinarias, misteriosas y peculiares. Algunas, han hecho algo de difícil explicación, otras parece que se han tele transportado y otras simplemente han desaparecido para siempre, hoy veremos las 5 más increíbles…
2017-04-1211 min
RCENIEl impresionante secreto de Nikola Tesla detrás de los números 3,6 y 9"Si supieras la magnificencia de los números tres, seis y nueve, tendrías una llave al universo.” – Nikola Tesla
2017-04-1209 min
RCENIPlaneta Vivo,. La casa del Árbol de Turín.Diseñado por el arquitecto Luciano Pia, el inmueble recibe el nombre de 25 Verde y es un intento de evadir la homogénea escena urbana de la ciudad e integrar la naturaleza en la fachada arquitectónica en la que se entretejen exuberantes árboles y vigas de acero que permiten a los residentes sentirse como si vivieran en una casa
2017-04-0903 min
RCENI5 Minutos para la Cooperación.- Reforma Educativa en Bolivia.Intered colabora con la ONG boliviana CEMSE, en la implantación de la reforma educativa boliviana. A través de iniciativas para el fomento de la investigación y la lectura, pretenden impulsar un cambio en el modelo educativo que traspase las aulas y llegue al conjunto de la comunidad.
2017-04-0905 min
RCENIPaíses en conflicto - Ataques aéreos contra civilesDesde 1945, más del 80% de las víctimas de los conflictos son civiles. En la actualidad, las leyes de la guerra son violadas sistemáticamente en países como Siria, Irak o Yemen.
2017-04-0913 min
RCENIINCREÍBLES BATALLAS ENTRE OVNIS Descritas en Textos AntiguosExisten multitud de relatos en textos antiguos, que describen, con gran detalle, batallas en los cielos, protagonizadas por objetos voladores no identificados, que causaron pánico y terror entre la población.
No se sabe de dónde procedían si del interior de la tierra, de otras dimensiones o del espacio exterior.
Ni tampoco por qué las batallas tenían lugar en nuestro planeta, ¿acaso se disputaban su dominio?
Si en la antigüedad no tenían ningún inconveniente en mostrarse ante la población y causar terror entre sus habitantes ¿Por qué no los vemos ahora? ¿Por qué se esconde...
2017-04-0310 min
RCENIVenezolanos sin Fronteras.- Datos de la adaptación de los venezolanos en el extranjero.Si bien es cierto una diáspora no es ningún evento favorable, también es agradable saber que muchos venezolanos se han adaptado estupendamente y crean nuevas oportunidades de trabajo y negocios. Que definitivamente contribuyen a crecimiento de país que los ha acogido.
2017-04-0259 min
RCENIPlaneta Vivo.- Aves y cambio CimaticoComo bien sabéis, el cambio climático está modificando los hábitats naturales y afecta de forma desigual a las especies del planeta. Lo nuevo es que, según un reciente estudio internacional publicado en la revista Science, el aumento de temperaturas está alterando de forma desigual las poblaciones de aves. Se ha analizado la evolución de más de medio millar de especies de Europa y Estados Unidos (145 europeas y 380 estadounidenses) y se ha comprobado que las más habituales en ambientes frescos sufrirán una regresión mientras que las típicas de climas más cálidos podrí...
2017-04-0202 min
RCENI5 minutos para la Colaboración.- Inundaciones en PerúAcción contra el Hambre es una de las organizaciones que actúa, gracias al convenio con la Agencia Española de Cooperación Internacional (AECID), en Perú, para ayudar a paliar los efectos devastadores de las lluvias. Entrevistamos al director de Acción contra el Hambre en Perú, Iván Baztán.
2017-04-0205 min
RCENIPaíses en conflicto - Un año del acuerdo UE - Turquía en materia migratoria.El 20 de marzo de 2016 entró en vigor el acuerdo firmado entre la Unión Europea y Turquía en materia migratoria. Un año después, Médicos Sin Fronteras denuncia el impacto que está teniendo en los miles de atrapados así como sus condiciones de vida.
2017-04-0211 min
RCENI180 grados.-Chuck Berry,Tenis y FeistSabíamos que no era inmortal, pero su música si lo será. Como no podía ser de otra forma abrimos con Chuck Berry y 'You never can tell', y otro de sus himnos, 'Roll Over Beethoven' en la versión de uno de sus discípulos, M. Ward. Escuchamos 'Pleasure', la canción que adelanta y da título al nuevo disco de Feist. Y damos la bienvenida a la primavera con las canciones de Wavves, The Drums, Tennis, Beach Fossils, Real Estate y más.
PLAYLIST: CHUCK BERRY - 'You never can tell'; M WARD - 'Roll Over Beet...
2017-03-3159 min
RCENI5 minutos para la Cooperación - Comunicación para el cambio socialNo sólo es suficiente con recorrer el mundo para mejorarlo. Aquí, en los países ricos, hay mucho también por hacer en cuanto a sensibilización para lograr el verdadero cambio social que necesitamos. El taller online 'Escribir desde terreno' ofrece claves para trasladar mejor lo que ocurre lejos, con un enfoque menos técnico y más personal.
2017-03-2805 min
RCENIPlaneta Vivo.- Papel reciclado en la oficinaDesde la implantación de la factura electrónica las empresas españolas generan casi 60 millones de recibos electrónicos en tan sólo seis meses con un ahorro de más de 450 millones de euros y 250.000 horas de trabajo reiterativo. En la administración pública, la implantación de la factura que ahorra tinta y papel tiene un beneficio anual de más de 50 millones, según un estudio de Seres. El coste medio de recepción de una factura electrónica es 4,95 euros menos que en papel y además de su impacto económico, su uso ha evitado la t...
2017-03-2702 min
RCENIPaíses en conflicto - Mujeres de SiriaLas mujeres de Siria están reclamando su participación en la mesa de negociación para alcanzar una solución política al conflicto. Y que sus reivindicaciones sean atendidas en el post-conflicto como han venido haciendo desde antes de marzo de 2011
2017-03-2712 min
RCENICurioso Mundo.- Datos interesantes y curiosos del MundoUn recorrido muy ameno por una buena cantidad de datos, iniciando por nuestro cerebro y terminando con el universo.
2017-03-2107 min
RCENI5 minutos para la cooperación.- Educación en Emergencia.Nos acercamos al proyecto de Educación en emergencia de la Comisión Europea con su portavoz para Acción Humanitaria y Desarrollo, Carlos Martín Ruiz de Gordejuela.
2017-03-2004 min
RCENIPlaneta Vivo.- Ballenas GrisesNi las gélidas aguas en las que viven, con temperaturas de hasta 45 grados bajo cero, les congelan la sonrisa. Las últimas ballenas grises occidentales, enormes como un autobús urbano, de 14 metros de longitud y 40 toneladas de peso, son tan amigables que hasta se dejan acariciar el hocico que acercan a las embarcaciones ante la sorpresa de sus tripulantes.
Tiene motivos añadidos para ser feliz. La ballena gris ha vencido a los principales bancos del mundo. Una campaña ecologista les ha obligado a condicionar un préstamo al gigante petrolero y gasístico Shell. Cuál es la condi...
2017-03-2002 min
RCENI180 Grados - Satellite Stories, Weezer, Elephants From Neptune y The XX -Empezamos con 'Radiant', la nueva canción de Satellite Stories y anunciamos que vuelven a España. Seguimos con la canción del verano de Weezer, 'Feels Like Summer', volvemos a escuchar 'NM' de Niños Mutantes y nos hacemos eco del momento -para la posteridad- que se produjo en Londres cuando The XX, en concierto, invitaron a Florence Welch a cantar con ellos 'You've Got The Love'. Aparte, conocemos a un cuarteto llamado Elephants From Neptune con 'Oh No'.
2017-03-1929 min
RCENIPaíses en conflicto - Refugiados de AfganistánSaboor es un periodista afgano que huyó de su país amenazado por los talibanes. Tras cruzar el Egeo fue detenido y golpeado en Hungría. Ahora espera en Suiza la respuesta a su solicitud de asilo. Desde enero de 2016 casi 800.000 refugiados afganos han retornado o han sido deportados, la mayoría desde Pakistán.
2017-03-1610 min
RCENIMundo Curioso…10 Curiosidades de la TierraLa tierra es el hogar de más de 7 mil millones de personas, y actualmente es el único lugar en el universo que es capaz de albergar vida como la conocemos en sus distintas formas, colores y tamaños, y aunque es el lugar en donde vives seguramente desconoces muchos de estos datos interesantes que escucharemos a continuación.
2017-03-1406 min
RCENIFonoteca ...Violeta ParraEl 5 de febrero de 1967 se suicidó la cantautora chilena Violeta Parra, en pleno reconocimiento del público y en el mejor momento de su vida artística, un año después de haber compuesto la inmortal canción “Gracias a la vida”. Violeta Parra cantó la libertad, el amor y la paz, así como su rabia contra la injusticia, la religión y los poderes dominantes. Cantante, poetisa, compositora, pintora, escultora, bordadora, ceramista… su legado artístico permanecerá por siempre.
2017-03-1328 min
RCENI¿El efecto Mandela al quien está cambiando la Realidad¿Sabe usted que es el efecto Mandela? Qué haría si al despertar su entorno no es el mismo al acostumbrado?
Así como, cambios en títulos de películas y programas de televisión; va y conversa con sus amistades y familiares.
Nota que tiene recuerdos de eventos distintos a ellos pero nunca ocurrieron?.
De la misma manera, que el mundo ha cambiado, al igual en la memoria y sucesos, teniendo recuerdos de una realidad alterna;
Es lo que es conocido como el Efecto Mandela.
Origen del Efecto Mandela
Para comprender este efecto es necesario conocer su origen.
En el año...
2017-03-1316 min
RCENI180 grados - Father John Misty, The New Pornographers, Bisagra y Alt J -Father John Misty se encarga de inaugurar la hora de hoy con 'Total Entertainment', seguimos con la última de las canciones del nuevo disco de Juan Zelada, estallan Idealipsticks y llegan, desde Atlanta las chicas de The Coathangers. Escuchamos lo nuevo de Flock Of Dimes y otra de las canciones de Sondre Lerche antes de dar paso a lo nuevo de The New Pornographers: 'This Is The World Of Theater'. Recordamos 'Neon Bible' de Arcade Fire en su décimo aniversario, Leyre Guerrero nos trae la nueva (y preciosa) canción de Alt J y nos vamos a Granada para esc...
2017-03-1258 min
RCENIPlaneta Vivo.- Eficiencia energética IfemaIfema ha acogido estos días cuatro ferias profesionales, cuyo hilo conductor ha sido la eficiencia energética y la innovación. Con cerca de un millar de empresas participantes han sido Genera, dedicada a la energía y medioambiente, climatización y refrigeración, a las instalaciones de frío y de calor, SIGA, a la tecnología del agua, y Tecnova, a las piscinas e instalaciones acuáticas.
La eficiencia y el diseño vanguardistas para el hogar marcan el sector con equipos de aire acondicionado con sensores inteligentes para menor consumo y mayor protección del medioambiente; módulos híb...
2017-03-1102 min
RCENI5 MINUTOS PARA LA COLABORACION.- Reconstruir la SanidadFarmacéuticos Sin Fronteras ha trabajado durante un año en Nepal, la reconstrucción de un dispensario médico destruido por el terremoto de 2015. Está situado en el distrito de Dhading, da cobertura a más de 15.000 personas y forma parte de un proyecto de asistencia sanitaria que pretende recuperar y extender la atención médica
2017-03-1104 min
RCENIPAISES EN CONFLICTO.- Día de la MujerAsha lucha contra la mutilación genital femenina que ella misma sufrió. Rachana, contra el matrimonio infantil del que logró escapar. Oula, por el cambio y los derechos humanos en su país. Las balas no acallaron la voz de Berta, la multiplicaron.
2017-03-1115 min
RCENIRusia Informa Sobre la Vida Extraterrestre en su Canal de NoticiasRusia informa sobre la vida extraterrestre en su Canal de Noticias y advierte que Rusia y estados Unidos deben informar al mundo sobre la vida extraterrestre y sus constantes visitas a nuestro planeta.
2017-03-0609 min
RCENI180 grados.- The Drums, Wavves ,toothless y Cold PlayThe Drums regresan subidos a la ola y al buen rollo de sus primeras composiciones con 'Blood Under My Belt' y hoy ocupan nuestra portada. Seguimos con Beck y el anuncio -por fin- de su nuevo disco y llegamos a lo nuevo de Wavves, pop inmediato bajo el título de 'Daisy'. En el ecuador del programa, escuchamos otra de las canciones Toothless y terminamos la sesión con la nueva canción de Coldplay en el día del 40 cumpleaños de Chris Martin
THE DRUMS - Blood Under My Belt, BECK - Dreams, WAVVES - Daisy, BEAROID - At Yo...
2017-03-0558 min
RCENIPlaneta Vivo.- Árbol ArtificialUn árbol artificial que convierte el viento en electricidad. Se llama NewWind y gracias a su forma y su tamaño se integra en el paisaje urbano. Capta la energía eólica a través de las hojas. Cada una de ellas es un aerogenerador pequeño, pero, eficiente. Estas hojas artificiales, llamadas Aeroleaf, funcionan como una red local de pequeños aerogeneradores. Individualmente producen unos pocos vatios de electricidad, pero, en conjunto, suman hasta 3 kW de potencia eléctrica, dependiendo de su configuración.
2017-03-0502 min
RCENI5 Minutos para la colaboración.- Salud para GuatemalaNos acercamos al trabajo que Médicus Mundi realiza desde hace años en Guatemala donde apoyan a la administración para ayudar a levantar un sistema sanitario que alcance a todos, especialmente a las minorías que viven lejos de los grandes núcleos.
2017-03-0404 min
RCENIPAISES EN CONFLICTO.- Berta CáceresBerta Cáceres defendió durante años la tierra y el medio ambiente. Una lucha que, según denuncian familiares y compañeros activistas, le costó la vida. Su asesinato ha puesto de manifiesto el riesgo que asumen los defensores de derechos fundamentales en Honduras, el país más peligroso del mundo para quienes ejercer esa labor
2017-03-0411 min